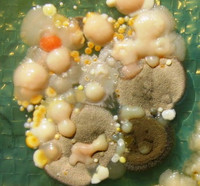
Mixed culture of molds

Bioengineering activities specifically involving biological agents ( for example bacteria or viruses) pose risks such as infections and allergies for workers (see also the German Ordinance on Safety and Health Protection at Workplaces Involving Biological Agents). A comprehensive package of European standards focuses on measures such as technical and organisational procedures to prevent such risks, particularly in the area of biotechnology. Product standardization relating to work equipment such as microbiological safety cabinets plays an important role in this context. Tasks involving incidental contact with biological agents, such as in composting plants or medical laboratories, are also subject to OSH-related standardization (for example by way of the development of measurement methods for the detection of certain biological agents). Also useful in this context is the database of biological agents maintained by the DGUV, BG RCI and the Federal Ministry of Labour and Social Affairs: www.dguv.de/ifa/gestis-biological-agents.
The KAN Secretariat has also addressed standardization of infection protection masks (see KANBrief 1/2022). A new series of standards for masks is being developed at European level. It is to contain test procedures for protection of the wearer and other persons against airborne pathogens. Since these infection protection masks could also be used to protect employees, occupational safety and health stakeholders consider this standardization project highly significant.